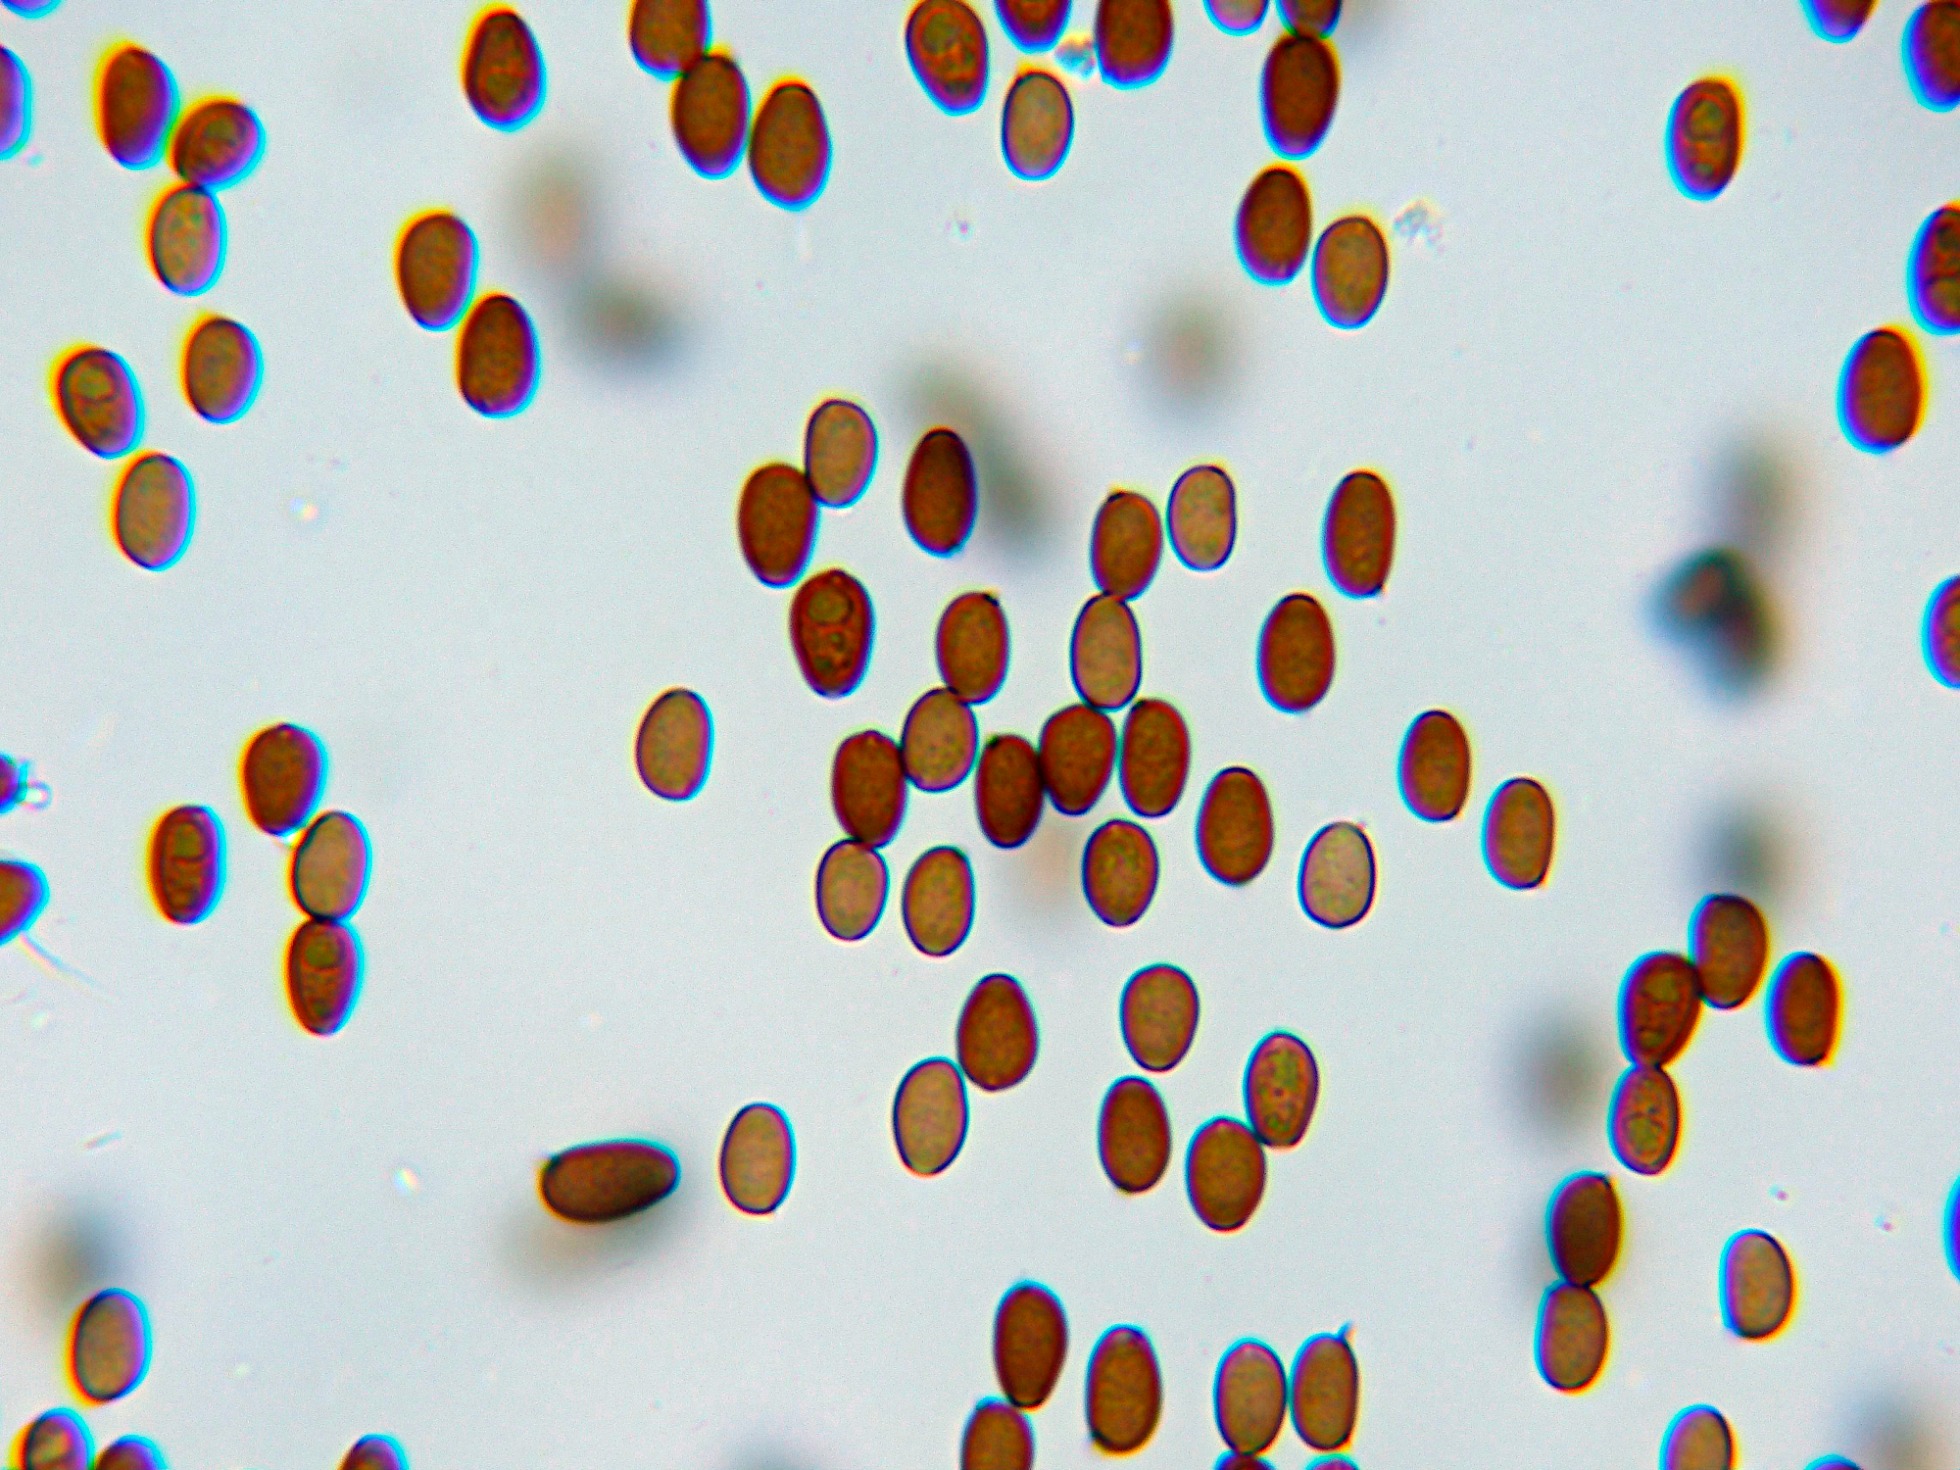
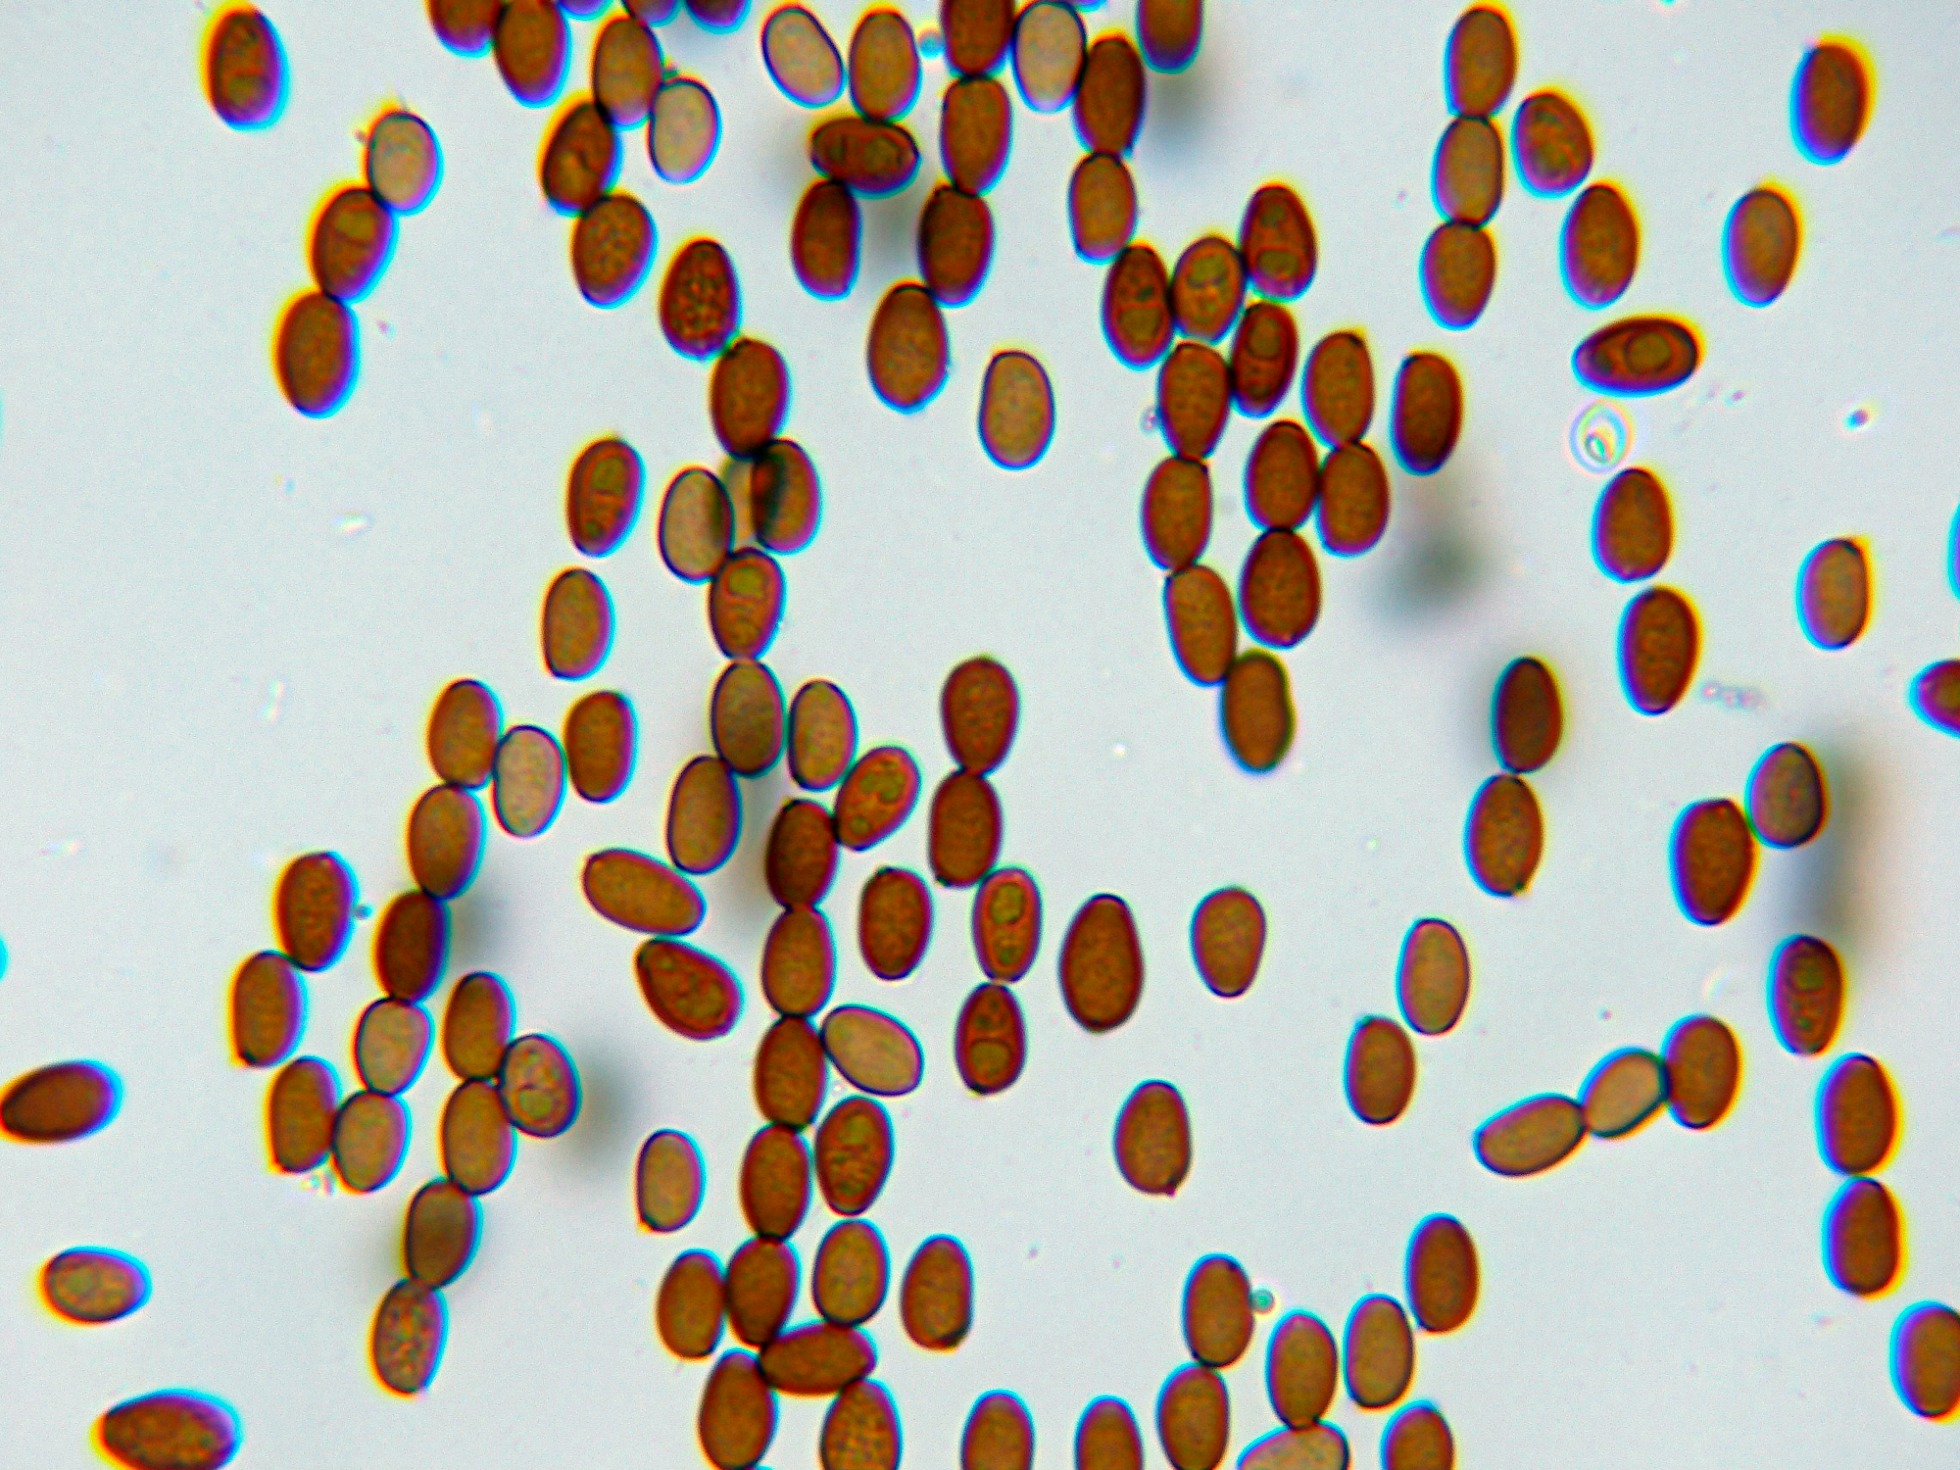

- Foro
- Foros sobre Micología de fungipedia
- Microscopía
- Psathyrella panaeoloides (Maire) Arnolds. Microscopía.
 Psathyrella panaeoloides (Maire) Arnolds. Microscopía.
Psathyrella panaeoloides (Maire) Arnolds. Microscopía.
- Josep Torres
-
 Autor del tema
Autor del tema
- Fuera de línea
- Moderador
-

Menos
Más
- Mensajes: 8746
- Gracias recibidas: 8379
3 años 9 meses antes #107499
por Josep Torres
Hola a tod@s.
Un solo ejemplar fotografiado en campa de altura el 15 de Mayo de este año.
En su estudio al observar una gran cantidad de cristales en todos los tejidos de las muestras preparadas, me surgieron dudas sobre su identidad, al igual que en otras ocasiones ante la más mínima duda suelo recurrir al análisis molecular el que determinó que se trataba con una coincidencia del 100% de Psathyrella panaeoloides LR875126.
Psathyrella panaeoloides (Maire) Arnolds
Un solo ejemplar aislado con un sombrero higrófano que no llegaba ni a los 2 cm., con distribución radial de fibrillas.
Láminas medianamente espaciadas, de color pardo con reflejos violáceos.
Sus abundantes cristales en agua y a 400 aumentos.
Estos cristales no se diluyen en KOH.
Cristales en KOH a 1000 aumentos.
Suprapellis celulósica en Rojo Congo diluído:
Hifas del estípite a 400 aumentos, con algunas hifas terminales anchas.
Queilocistidios en amoníaco:
Pleurocistidios dispersos con una morfología parecida a los queilocistidios, los pleurocistidios en Rojo Congo diluído:
Sus basidios tetraspóricos:
Los basidios en KOH:
Las esporas obtenidas por esporulación natural y en agua:
Las esporas en Reactivo de Melzer, prácticamente sin reacción alguna:
Las esporas en amoníaco, con un oscurecimiento a marrón oscuro:
Y por último las esporas en KOH, de color gris oscuro:
Las esporas en agua con unas medidas de:
(7.4) 7.6 - 8.8 (9.6) × (4.7) 4.8 - 5.5 (6) µm
Q = (1.4) 1.5 - 1.7 (1.9) ; N = 40
Me = 8.2 × 5.2 µm ; Qe = 1.6
Observaciones: En este caso admito que siguiendo las Claves, dadas sus características su determinación no habría resultado extremadamente difícil, el único motivo por el que opté por la secuenciación fue por la gran cantidad de cristales observados, este dato por mucho que he buscado en la bibliografía, no lo cita ningun autor en la descripción de la especie aquí descrita.
Saludos a tod@s.
Un solo ejemplar fotografiado en campa de altura el 15 de Mayo de este año.
En su estudio al observar una gran cantidad de cristales en todos los tejidos de las muestras preparadas, me surgieron dudas sobre su identidad, al igual que en otras ocasiones ante la más mínima duda suelo recurrir al análisis molecular el que determinó que se trataba con una coincidencia del 100% de Psathyrella panaeoloides LR875126.
Psathyrella panaeoloides (Maire) Arnolds
Un solo ejemplar aislado con un sombrero higrófano que no llegaba ni a los 2 cm., con distribución radial de fibrillas.
Láminas medianamente espaciadas, de color pardo con reflejos violáceos.
Sus abundantes cristales en agua y a 400 aumentos.
Estos cristales no se diluyen en KOH.
Cristales en KOH a 1000 aumentos.
Suprapellis celulósica en Rojo Congo diluído:
Hifas del estípite a 400 aumentos, con algunas hifas terminales anchas.
Queilocistidios en amoníaco:
Pleurocistidios dispersos con una morfología parecida a los queilocistidios, los pleurocistidios en Rojo Congo diluído:
Sus basidios tetraspóricos:
Los basidios en KOH:
Las esporas obtenidas por esporulación natural y en agua:
Las esporas en Reactivo de Melzer, prácticamente sin reacción alguna:
Las esporas en amoníaco, con un oscurecimiento a marrón oscuro:
Y por último las esporas en KOH, de color gris oscuro:
Las esporas en agua con unas medidas de:
(7.4) 7.6 - 8.8 (9.6) × (4.7) 4.8 - 5.5 (6) µm
Q = (1.4) 1.5 - 1.7 (1.9) ; N = 40
Me = 8.2 × 5.2 µm ; Qe = 1.6
Observaciones: En este caso admito que siguiendo las Claves, dadas sus características su determinación no habría resultado extremadamente difícil, el único motivo por el que opté por la secuenciación fue por la gran cantidad de cristales observados, este dato por mucho que he buscado en la bibliografía, no lo cita ningun autor en la descripción de la especie aquí descrita.
Saludos a tod@s.
Adjuntos:
El siguiente usuario dijo gracias: Juan Andrés Román
Por favor, Identificarse para unirse a la conversación.
- Juan Andrés Román
-

- Fuera de línea
- Spammer
-

Menos
Más
- Mensajes: 2558
- Gracias recibidas: 2756
3 años 9 meses antes #107508
por Juan Andrés Román
Respuesta de Juan Andrés Román sobre el tema Psathyrella panaeoloides (Maire) Arnolds. Microscopía.
El siguiente usuario dijo gracias: Josep Torres
Por favor, Identificarse para unirse a la conversación.
- Josep Torres
-
 Autor del tema
Autor del tema
- Fuera de línea
- Moderador
-

Menos
Más
- Mensajes: 8746
- Gracias recibidas: 8379
3 años 9 meses antes #107515
por Josep Torres
Respuesta de Josep Torres sobre el tema Psathyrella panaeoloides (Maire) Arnolds. Microscopía.
El siguiente usuario dijo gracias: Juan Andrés Román
Por favor, Identificarse para unirse a la conversación.
- Foro
- Foros sobre Micología de fungipedia
- Microscopía
- Psathyrella panaeoloides (Maire) Arnolds. Microscopía.
Tiempo de carga de la página: 0.245 segundos

Foro de micología